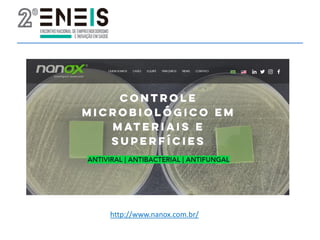
http://www.nanox.com.br/

O documento aborda o crescente interesse e investimento em healthtechs, com financiamento global de US$ 8,9 bilhões em 2019. Apresenta dados sobre o aumento de healthtechs no Brasil, destacando a importância de entender modelos de negócios, inovações e tecnologias no setor de saúde. Discutem-se também oportunidades e estratégias para o desenvolvimento de negócios baseados em tecnologia na área da saúde.